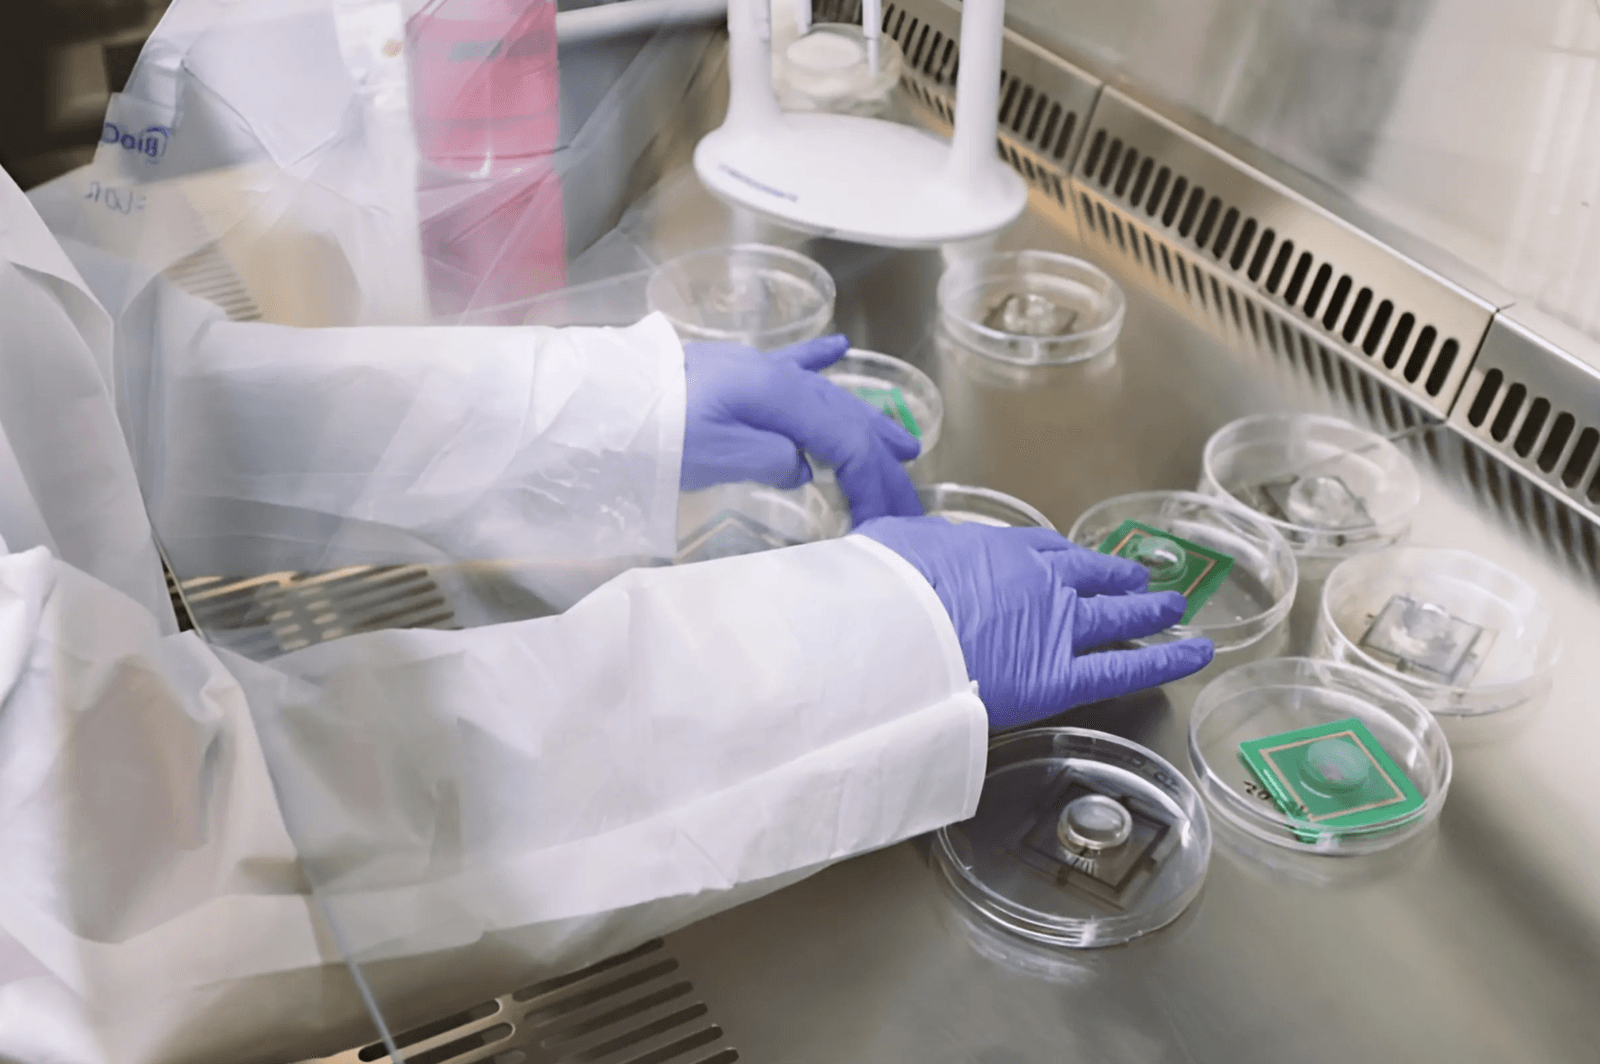

Obrazy, dźwięki i wrażenia sensoryczne z otaczającego świata są przekształcane w impulsy elektryczne, zanim nasz mózg będzie mógł je odebrać. Dzięki temu tkanka nerwowa jest wysoce kompatybilna z chipami krzemowymi, przynajmniej tak długo, jak długo można ją utrzymać przy życiu.
Szwajcarski start-up FinalSpark zbudował unikalny “żywy komputer” z 16 połączonych organoidów mózgowych (minimózgów) zbudowanych z ludzkiej tkanki. Z biokomputera Neuroplatform mogą skorzystać wszyscy badacze potrzebujący dostępu do sztucznej inteligencji, która zazwyczaj wymaga ogromnych zasobów.
Czytaj też: Po raz pierwszy stworzono minimózgi z tkanki płodu. Historia dzieje się na naszych oczach
Dr Ewelina Kurtys, doradca strategiczny FinalSpark, mówi:
Jedną z największych zalet obliczeń biologicznych jest to, że neurony przetwarzają informacje przy znacznie mniejszej energii niż komputery cyfrowe. Szacuje się, że żywe neurony mogą zużywać ponad milion razy mniej energii niż obecne procesory cyfrowe, których używamy.
Minimózgi podłączone do komputerów już tu są – każdy może z nich skorzystać
Organoidy mózgowe FinalSpark składają się z około 10 000 żywych neuronów i są hodowane z komórek macierzystych. Te małe kulki o średnicy około 0,5 mm są przechowywane w inkubatorach w temperaturze zbliżonej do temperatury ciała, zasilane wodą i składnikami odżywczymi oraz chronione przed patogenami, a następnie podłączane do obwodu elektrycznego za pomocą serii maleńkich elektrod.
Czytaj też: Podłączyli organoidy mózgowe do komputera. Efekt przerósł najśmielsze oczekiwania
Koncepcja żywych komputerów istnieje już od dłuższego czasu. Jakiś czas temu głośno było o australijskim urządzeniu DishBrain firmy Cortical Labs, które wykorzystuje 800 000 ludzkich komórek mózgowych wyhodowanych na chipach krzemowych. DishBrain nauczył się grać w Ponga w ciągu około 5 minut i wykazał się imponującymi możliwościami jako superwydajne narzędzie do uczenia maszynowego, przyciągając nawet fundusze wojskowe na dalsze badania. Zespół FinalSpark używa mniejszych organoidów połączonych w macierze, ale to daje nową opcję zalewania minimózgów hormonami (jak dopamina), gdy prawidłowo wykonają zadanie.

Dr Fred Jordan, współzałożyciel FinalSpark, mówi:
Zamykamy dopaminę w klatce molekularnej, początkowo niewidocznej dla organoidu. Kiedy chcemy “nagrodzić” organoid, wystawiamy go na działanie określonych częstotliwości światła. To światło otwiera klatkę, uwalniając dopaminę i zapewniając zamierzony bodziec dla organoidu.
To absolutnie dziwaczny obszar badań i z pewnością u niektórych budzi wątpliwości etyczne, ale zwolennicy żywych komputerów przekonują, że ludzie od dawna wykorzystują organizmy żywe do pracy. Dobrym przykładem są np. drożdże wykorzystywane do warzenia piwa i konie ciągnące maszyny rolnicze.

Pewnie wiele osób zastanawia się, czy te “twory” są świadome? Nikt tak naprawdę nie wie i prawdopodobnie nigdy nie będzie nigdy wiedzieć, bo zresztą sama natura świadomości pozostaje nieuchwytna. Biokomputery z pewnością mogą okazać się przydatne – zarówno jako wydajne platformy uczenia maszynowego, jak i narzędzia do testowania wpływu różnych leków na możliwości przetwarzania informacji w mózgu.
FinalSpark ma nadzieję, że inne instytucje wykorzystają ich Neuroplatform w celu rozwoju badań nad biokomputerami, jednocześnie pozycjonując to narzędzie jako kolejny krok w obliczeniach AI. W obliczu rosnącego zapotrzebowania firm zajmujących się sztuczną inteligencją na zasoby dla centrów danych, a także rosnących obaw o emisję dwutlenku węgla i zużycie wody, to nowatorskie podejście może się opłacić w dłuższej perspektywie.